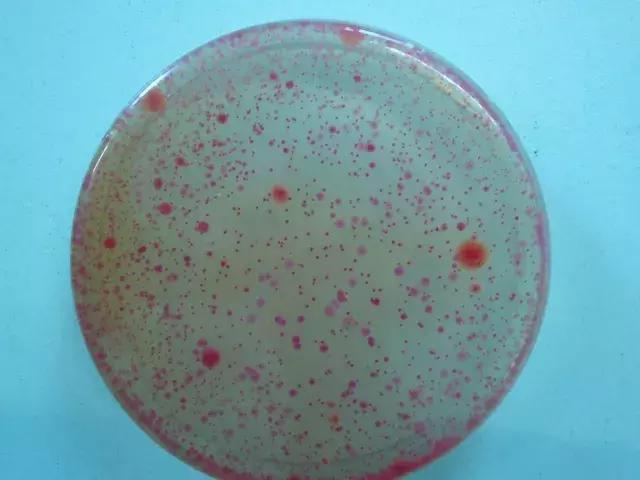
森田药妆面膜查出什么问题,森田面膜加入黑名单的是哪一款

每每皮肤状态不好
脑子里的第一个想法就是
面膜~面膜~面膜
几乎得了一种叫“离开面膜会死”的病

但最近几天喜真的是
夹缝里求生存!!!
不良商家年年有,今年特别多
每每入手一件化妆品都要小心翼翼

幸好药监局也是很给力
一次性公布了17家企业生产或代理的
27批次化妆品不合格通告

注意!注意!不是2、3个
而是27个
吓得我赶紧给大家去做功课
(原图就模糊,相信我尽力了!)



可

怕



经过地毯式的精扒
发现大多数牌子还是很陌生的
属于市场隐形款
突然醒悟了品牌的力量
不敢贪图快效便宜的款了

但让我意外地是
这一众陌生面膜里竟也有森田面膜!!
森田,你是怎么了?!!

森田也算迅速地做出回应
#森田道歉#迅速登上微博热搜
而且挂在热门上久久不下
(嗯……看来用过的妹子不少)

这一套公关流程
到是走得及时又诚恳
但,貌似这也不是第一次出事

介于森田是面膜大户
肯定也有不少宝宝囤了货
必须仔仔细细跟宝宝们叨叨

出事的是森田保湿精华水嫩面膜
批号和限期为HY161124085/2020.3.8
不合格项目为霉菌和酵母菌超标
一超就超了2.4倍

这是一个什么概念
一般霉菌的限定值是≤100CFU/g或CFU/ml
但森田的这款保湿精华水嫩面膜
菌值为240CFU/g
可以说是严重超标
脸都要变成霉菌的培养皿了(瑟瑟发抖)
在扒网友评论的时候
发现很多宝宝对着批次的面膜弄不明白
台湾产?还是上海产?
究竟哪个有问题


其实森田是一个台湾品牌
准确叫做森田药妆
而代理森田的上海公司
旗下的面膜统一品牌为“森田”

虽然道歉信上面的森田面膜上写着“森田”
但仔细扒就发现
国家药监局公布的信息中
这批面膜的产地为“台湾”
不论是森田药妆还是森田
侥幸心理请抛弃!慎入!毕竟本是同根生
当然,不代表森田所有面膜都有问题
见仁见智啦
反正下面这款绕道走就对啦

森田已经在主动召回出事批次的产品
并且对顾客进行了退换货处理
如果你抽屉有!就赶紧退
别留着当培养皿了

你以为森田把你当培养皿很过分?
生活中这样的面膜陷阱可真的不少
有的直接让你吃“皮肤*片鸦**”
有的让你直接变绿灯侠

这样的毒面膜一定要严肃拒绝
什么是毒面膜?
宝宝们谨记这几点

添加糖皮质激素是毒面膜
糖皮质激素又名“肾上腺皮质激素”
是由肾上腺皮质分泌的一类甾体激素
具有调节糖、脂肪和蛋白质的
生物合成和代谢的作用
还有,抗炎、抗毒、抗休克作用

从本质上来说,它并不是坏东西
但是添加到面膜里就不一样了
那简直就是皮肤*片鸦**呐
属于谁碰谁遭殃的那种~~~

短时间让你变白变嫩
起初可能没有明显症状,一旦停用
就会面部干燥刺痛瘙痒
产生黑斑、变薄等问题
长时间依赖会导致激素依赖性炎症
美容就变成了毁容啦

犹豫了半天
要不要放那些“可怕”的副作用图片
最后还是决定,保护泥萌的小心脏
胆大的宝宝可以搜索“激素脸”
百度图片上就有很多哦~

像这次公布的
氟轻松/倍他米松/氯倍他索丙酸酯
还有氢化可的松戊酸酯等
化妆品禁用物质都属于
糖皮质激素一员

其中膜法奇迹还有静距离是我常见
竟然也中招
真的是一次不忠一生黑

添加重金属是毒面膜
黑心的商家为了增加销量
无下限的在面膜中添加重金属
可能在美白等功效立竿见影
但对肌肤来说,就是一颗定时*弹炸**

这时候细心的宝宝会说
那卖得超级火的RAY面膜
为啥还可以这么吸粉

金的确也是重金属,但不是违禁成分
耐受的宝宝是有很好的护肤功效的
面膜重金属违禁成分主要是
铅&汞

添加荧光剂是毒面膜
荧光剂是一种荧光染料
通过发光的效应让脸看起来很白
到现在我仍记得几年前
一个受荧光面膜毒害的女孩照片

荧光剂不像一般化学成分那样容易被分解
而是在人体内蓄积
大大削减人体免疫力,阻碍伤口愈合
使人体细胞出现变异性倾向
甚至有潜在的致癌风险

如果家里有1秒变白的面膜
那可能不是面膜多厉害
而你就需要用紫外线照射灯照照
检测一下荧光剂了哦

看到这,宝宝们也别慌
毒面膜固然存在
但是踏踏实实的化妆品牌还是很多的
还是可以愉快地敷面膜

不过我们必须学会选择
学会拒绝三无产品
选择适合自己肤质的、品牌靠谱的货